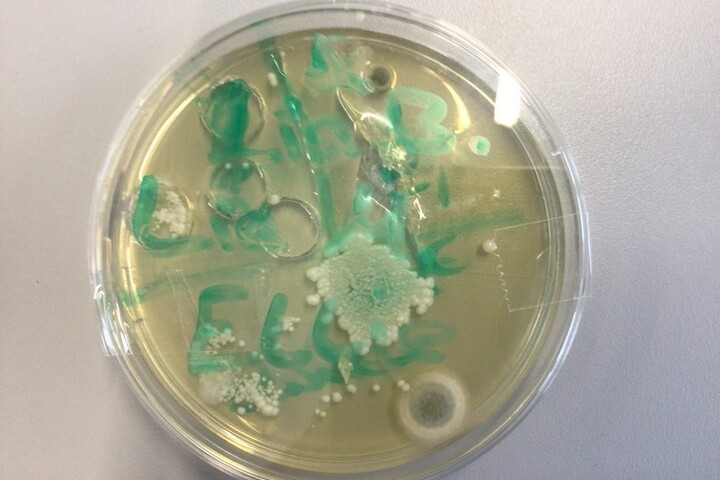

unsere Aktivitäten

„Seid ein Sonnenstrahl im Leben anderer“
Schülerinnen der Maria-Ward-Schule basteln Weihnachtsgeschenke für Senioren
Die Adventszeit ist eine besondere Gelegenheit, innezuhalten und an die Menschen zu denken, die
uns umgeben. Gerade in der Weihnachtszeit möchten wir nicht nur mit unseren Liebsten feiern,
sondern auch anderen eine Freude bereiten. Getreu diesem Gedanken machten sich die
Schülerinnen der 5. und 6. Klassen der Maria-Ward-Schule daran, für die Bewohnerinnen und
Bewohner der Seniorenresidenz in Zellingen etwas Einzigartiges zu gestalten.
Mit viel Kreativität und Herz bastelten die Schülerinnen liebevoll gestaltete Weihnachtskarten und ein
besonderes Geschenk: ein selbstgemachtes Sonnenmobile. Das Mobile, inspiriert vom Motto „Seid
ein Sonnenstrahl im Leben anderer“, soll den Beschenkten ein Lichtblick und ein Zeichen der Wärme
sein – gerade in den oft dunkleren Tagen des Winters.
Die Übergabe der Geschenke fand in einer ebenso herzlichen Atmosphäre statt. Die
Klassensprecherinnen der beteiligten Klassen besuchten das Seniorenheim persönlich und
überreichten die Geschenke den Bewohnerinnen und Bewohnern. Die Freude war auf beiden Seiten
groß: Die älteren Menschen zeigten sich sichtlich gerührt über die liebevollen Gesten, während die
Schülerinnen stolz darauf waren, etwas so Wertvolles beigetragen zu haben.
Diese Aktion zeigt einmal mehr, wie einfach es sein kann, mit kleinen Gesten große Freude zu bereiten.
Sie stärkt nicht nur das Gemeinschaftsgefühl, sondern erinnert uns daran, wie wichtig es ist,
füreinander da zu sein.
Ein großes Dankeschön gilt allen Schülerinnen, die mit Begeisterung und Einsatz an diesem Projekt
teilgenommen haben, sowie den Lehrerinnen und Lehrern, die die Schülerinnen unterstützt und
begleitet haben. Möge das Sonnenmobile ein Symbol dafür sein, dass auch kleine Sonnenstrahlen
das Leben anderer erhellen können.
In diesem Sinne wünschen wir allen eine besinnliche Weihnachtszeit!
E. Fehrer



Besuch der Klassen 9a,b und c im CrossFit
„Mach Dich fit!“. Unter diesem Leitspruch steht das Sportlehrjahr der neunten Klassen. Im Rahmen des Sportunterrichts durften deshalb alle neunten Klassen ein kostenloses Probetraining im CrossFit Würzburg absolvieren. Da der Besuch eines Fitnessstudios ab 14 Jahren gestattet ist, war das Zirkeltraining für die meisten die erste Erfahrung im Kraftsport, für viele aber mit Sicherheit nicht die letzte! In diesem Sinne: Bleibt fit und weiterhin „Full Power“! L. Thalmann


Bücherfreunde AG
Wer sind die Bücherfreunde? Wir sind eine kleine Gruppe von Mädels, die sich gerne mit dem Thema Bücher und allem was dazugehört beschäftigen: Bücher lesen, basteln mit alten Büchern, Buchgeschäfte besuchen usw. Wir treffen uns einmal die Woche in der Bibliothek und haben z. B. die Aktion „Blind Date with a book“ gestartet, bei der wir Romane verpackt haben, so dass man das Cover nicht sieht, nur unsere Indizien zu den Inhalten der Bücher, die wir auf das Papier gezeichnet haben. Die Bibliotheksbesucherinnen sollen ihre Lektüren nicht nur aufgrund des Covers oder bisheriger Vorlieben ausleihen, sondern durch das „Überraschungspäckchen“ vielleicht Gefallen an neuen Genres finden. Außerdem waren wir neulich in der Bücherei am Hubland und haben uns Zeit genommen die dortige Bibliothek zu erkunden. Nach einer kleinen Büchereirally haben wir es uns natürlich auch in den gemütlichen Leseecken bequem gemacht und in dem ein oder anderen Buch geschmökert. Wer Lust hast, noch an der AG teilzunehmen, kann sich jederzeit an Frau Brückner wenden.
M. Brückner


Unsere Schülerinnen der zehnten Klassen informieren sich für ihre Zukunft
Interessierte Schülerinnen der zehnten Klassen und deren Eltern konnten am Dienstag, den 17. Dezember 2024 nach Unterrichtsschluss exklusive Informationen zum Übertritt an die FOS erhalten. Hierzu besuchte Frau von Groll, die Beratungslehrkraft der FOS Würzburg, die Maria-Ward-Schule und gab den Schülerinnen einen Einblick in die verschiedenen Möglichkeiten der Zweigwahl sowie die Voraussetzungen für den Übertritt. Frau von Groll zeigte die Prüfungsfächer der fünf Ausbildungsrichtungen und stellte eine mögliche Schullaufbahn an der FOS vor. Zudem wurde der Unterschied der verschiedenen Schulabschlüsse sowie die weiteren Möglichkeiten im Hinblick auf verschiedene Studiengänge und Universitäten erklärt. Unsere Schülerinnen hatten im Anschluss an den Vortrag noch Zeit, ihre persönlichen Fragen zu äußern.
Ein herzliches Dankeschön geht an Frau von Groll für Ihren Besuch an unserer MWS.
A. Spindler


Die SMV verschönert die Adventszeit
HoHoHo liebe MWS-Familie,
der Dezember ist schon im vollen Gange und das bedeutet: Weihnachten ist nicht mehr weit entfernt und wir stecken mitten in der Adventszeit 🎄✨
Auch wir von der SMV haben wieder einiges für euch vorbereitet, um euch die Vorweihnachtszeit etwas zu verschönern.
Am 28.11.24 hatten wir einen riesigen Plätzchenverkauf, mit zahlreichen und leckeren Plätzchensorten. Vielen lieben Dank, an alle fleißigen Bäckerinnen. Das habt ihr wirklich toll gemacht! Als Belohnung hat uns dann auch am 06.12.24 der Nikolaus mit seinen Engeln besucht. Jede Schülerin hat von ihm eine Mandarine und eine Schokolade bekommen.
Auch in diesem Jahr nimmt unsere Schule wieder an der Weihnachtspost teil, wo Weihnachtsbriefe in und unter den Würzburger Schulen verteilt werden. Die Briefe können bis 10.12.24 abgegeben werden und werden am 13.12. an die anderen Schulen verteilt.
Die Interne Weihnachtspost wird am letzten Schultag vor den Ferien verteilt.
Wir wünschen euch und euren Familien eine besinnliche Adventszeit, wunderschöne Weihnachtstage und tolle Ferien 🎄✨🎁
Eure Schülersprecherinnen,
Zoe, Mathilda und Melina


Irlandaustausch
Vom 06.-13.10.2024 hatte die MWS Besuch von zehn irischen Austauschschülerinnen der Loreto Secondary School aus Bray.
Am späten Sonntagnachmittag nahmen wir, Schülerinnen der 8. Jahrgangsstufe, unsere Gastschülerinnen in Empfang und hießen sie in den jeweiligen Gastfamilien willkommen.
Die Woche war von den betreuenden Lehrerinnen, Frau Rüttger und Frau Brückner, sehr gut vorbereitet und geplant. Die irischen Mädchen haben mit uns gemeinsam den Unterricht besucht und verschiedene Aktivitäten unternommen. Wir haben unter anderem die Residenz besichtigt, sind nach einer Schifffahrt auf dem Main durch den Veitshöchheimer Rokkokogarten geschlendert, waren im schönen Bamberg und wurden auch im Würzburger Rathaus begrüßt. Aus der Schulküche wurden wir vom EG-Zweig bekocht bzw. bebacken und die Irinnen konnten die deutsche Küche kennenlernen.
Zwischendurch haben wir unsere Freizeit genutzt und die verschiedensten Dinge unternommen: Manche sind in kleinen Gruppen durch Würzburg gebummelt, andere waren beim Bowlen, im Kino oder haben sich privat getroffen.
Am Samstag, der als Familientag geplant war, konnte jeder mit seiner Austauschschülerin zusammen den Tag selbst gestalten.
Ich selbst war mit Ellie auf der Geburtstagsfeier meines Cousins und wir hatten bei gemeinsamen Spielen jede Menge Spaß.
Nach einem ausgiebigen Sonntagsfrühstück mussten wir leider Abschied nehmen. Am Bahnhof in Würzburg waren zum Glück alle pünktlich beim Treffpunkt und nach einem Gruppenfoto ging es für die irischen Gäste wieder zurück nach Hause.
Wir freuen uns sehr auf den Besuch in Irland im nächsten Jahr und sind schon sehr gespannt :-)
llka Ernst, 8 a



Adventsverkauf an der Maria-Ward-Schule
Am Mittwoch, 11. Dezember, sowie am Mittwoch, 18. Dezember, fand in den Pausen der diesjährige Adventsverkauf statt, organisiert vom Fairtrade-Team der Schule. Neben fair gehandelten Produkten wie Tee, Cookies, Schokoriegeln und weiteren kleinen Geschenkideen aus dem Würzburger Weltladen gab es in diesem Jahr auch selbst hergestellte faire Schokolade, über die sich viele Schülerinnen besonders freuten. Viele nutzten die Gelegenheit, um kleine Geschenke für die Weihnachtszeit zu kaufen.
Am Verkaufsstand selbst gab es außerdem Informationen zu den Arbeitsbedingungen auf Kakaoplantagen in Form von Plakaten und Flyern, um auf die Bedeutung des fairen Handels aufmerksam zu machen.
Das Fairtrade-Team freut sich über die Unterstützung und das Interesse der Schülerinnen und Lehrkräfte, die mit ihrem Einkauf einen wichtigen Beitrag zum fairen Handel geleistet haben.
S. Küstner und M. Brückner



Dubai Schokolade selbstgemacht
Die Schülerinnen haben in einem kreativen Projekt die "Dubai Schokolade" hergestellt. Diese handgemachte Schokolade kombiniert exotische Zutaten und spiegelt das Engagement und die Kreativität der Schülerinnen wider. Ein köstliches Ergebnis!
G. Deubel


„More than care“ an der Uniklinik Würzburg: Realschülerinnen der Maria-Ward-Schule entdecken die Pflegewelt
Am letzten Schultag vor den Herbstferien lud die Uniklinik Würzburg zu einem besonderen Projekttag ein. Dieser Tag bot der 9. Jahrgangsstufe die Gelegenheit, erste Einblicke in den facettenreichen Uniklinik-Alltag zu gewinnen und sich intensiv mit den verschiedenen Aufgaben und Anforderungen auseinanderzusetzen, die eine Tätigkeit in der Gesundheits- und Krankenpflege mit sich bringt.
Verschiedene Stationen, die von Praxisanleiterinnen und erfahrenen Pflegekräften betreut wurden, boten den Jugendlichen spannende Einblicke in den Unialltag: So lernten wir, wie man Vitalzeichen misst, die Schülerinnen durften Verbände anlegen, es wurden Babypuppen gewickelt, wir schnupperten in der Aromakunde, es wurden Zugänge gelegt, Keime und Bakterien unter dem UV-Licht gesucht, OP-Kittel angezogen und OP-Besteck inspiziert. Sehr anschaulich wurde die Implantation eines Stents bei einem Herzinfarkt beschrieben. Bei der Station der Beatmung wurde von der klassischen Reanimation an einem Dummie bis hin zum automatischen Beatmungsgerät alle Variationen gezeigt (und wer wollte, durfte dies auch selbst ausprobieren). Sehr viel Spaß bereitete den Schülerinnen der Rollstuhlparcour oder auch der Versuch auf Krücken zu laufen.
Beim reichhaltigen Buffet konnten viele Fragen mit dem “More than Care”-Team der Uniklinik geklärt werden.
U. Kaußler und M. Brückner




Einfach vorlesen! - Vorlesewettbewerb der 6 a und 6 b
Spannung lag in der Luft, als die beiden 6. Klassen mit ihren Siegerinnen zum Schulentscheid in der Aula zusammenkamen. Schon einige Wochen vorher stellten alle Mädchen der 6. Klassen vor ihren Mitschülerinnen unter Beweis, wer denn nun am deutlichsten lesen und gut betonen kann. Beide Klassen wählten daraufhin eine Klassensiegerin.
Eine fünfköpfige Jury, bestehend aus den Schülersprecherinnen Melina Roscher und Mathilda Keßler, den beiden Deutschlehrerinnen der 6. Klassen Frau Deckelmann und Frau Geiger sowie der Schulleiterin Frau Thum-Feige, hatten jetzt die schwere Aufgabe zu entscheiden, wer denn nun am besten vorlesen kann.
So startete Amelie Ganz (6 a) als erste Leserin. Sie hatte eine Stelle aus „Das Vermächtnis der Schokomagie“ von Mareike Allnoch vorbereitet, während Anna Weis aus der 6 b etwas aus „Keeper oft the lost cities“ von Shannon Messenger vorlas. Zur Entscheidung wurde dann noch je eine Stelle aus einem den Mädchen vorher nicht bekannten Jugendbuch („Mehr als ein Spiel“ von Sigrid Zeevaert) vorgelegt.
Auf ihren Bewertungsbögen vergab die Jury Punkte für Lesetechnik, Interpretation und die Textstellenauswahl.
Amelie Ganz aus der 6 a gewann ganz knapp den Vorentscheid zum Lesewettbewerb. Sie wird nun als Schulsiegerin zum Stadtentscheid geschickt und alle drücken ihr die Daumen, dass sie auch dort ihr Können unter Beweis stellen kann.
Beide Deutschlehrerinnen betonten nach der Veranstaltung, dass jedes der Mädchen wirklich gut gelesen habe und dankten ihnen sowie ihren Klassenkameradinnen für ihr Engagement.
V. Deckelmann


Fairtrade Schokolade
Anfang Dezember trafen sich die Schülerinnen der Fairtrade AG, um gemeinsam mit ihren Lehrkräften Frau Brückner und Herr Küstner so genannte Bruchschokolade aus fairen Zutaten herzustellen. In der Schulküche ging es nach der Mittagspause direkt an die Arbeit: Backbleche wurden vorbereitet und mit verschiedenen fair gehandelten Schokoladentafeln ausgelegt. Anschließend kamen sie zum Schmelzen in den Backofen, bevor die Schokoladenmasse am Ende mit einer Gabel marmoriert wurde. Nun ging es an die Verzierung mit Streuseln, Smarties, Mandeln, Zuckeraugen oder auch kleinen Salzbrezeln. Der Kreativität wurden hierbei keine Grenzen gesetzt. Nachdem die Schokolade fest geworden war, wurde diese in kleine Stücke geschnitten und umweltfreundlich in Butterbrotpapiertüten verpackt. Die Fairtrade AG hatte hierfür extra Tütchen sowie passende Aufkleber mit einem Logo designt. Am adventlichen Fairtrade Pausenverkauf wird es die Bruchschokolade zusammen mit anderen fair gehandelten Süßigkeiten und Geschenkchen für die Schulgemeinschaft zu kaufen geben. M. Brückner

Kreative Praxis im Biologieunterricht
Zellmodelle aus Knete
Im Biologieunterricht der 7. Jahrgangsstufe drehte sich in den letzten Wochen alles um das Thema Zellen. Doch statt nur trockener Theorie wurde es nun kreativ: Die Schülerinnen hatten die Aufgabe, Zellmodelle aus Knete zu gestalten! Mit bunten Farben und viel Fantasie entstanden detailreiche Modelle von tierischen und pflanzlichen Zellen. Ob Zellkern, Mitochondrien oder Zellwand – alles wurde präzise nachgebildet.
Dabei bewiesen unsere jungen Biologen nicht nur ihr Wissen, sondern auch handwerkliches Geschick. Mit viel Spaß lernten sie, wie die Bausteine des Lebens aufgebaut sind. Am Ende konnten alle stolz ihre Knetwerke präsentieren.
Auf Spurensuche nach Mikroorganismen - Abklatschversuche
Im Biologieunterricht der 8. Jahrgangsstufe ging es kürzlich auf spannende Spurensuche: Mit sogenannten Abklatschversuchen untersuchten die Schülerinnen, wo sich auf Alltagsgegenständen Mikroorganismen verstecken. Ob Türklinken, Handys oder Beauty-Artikel – mit speziellen Nährböden nahmen sie Proben von verschiedenen Oberflächen.
Nach einigen Tagen in warmer Umgebung, zeigte sich das faszinierende Ergebnis: winzige, oft unsichtbare Mikroorganismen hatten sich zu Kolonien entwickelt, die nun auf den Nährböden sichtbar waren. Die Schülerinnen staunten nicht schlecht, als sie die Vielfalt an Bakterien und Pilzen auf den Proben entdeckten. So wurde allen eindrucksvoll bewusst, wie wichtig Hygiene im Alltag ist.
Das Experiment brachte den Aha-Effekt – und den ein oder anderen dazu, sein Handy mal gründlich zu reinigen! L. Esteban


„Eine Schule, die Brücken baut“
Jedes Jahr zeichnet das Kultusministerium Schulen in Bayern für besondere Aktivitäten aus, die nicht unbedingt mit dem täglichen Unterricht zu tun haben. In diesem Jahr war die Maria-Ward-Schule ganz vorne dabei und belegte unter den unterfränkischen Realschulen einen beachtlichen dritten Platz. Zu einer Feierstunde mit Marcus Ramsteiner, dem Ministerialbeauftragten für die unterfränkischen Realschulen, hatten sich neben der Schulleitung um Birgit Thum-Feige und Vertretern des Stiftungsvorstandes, des Freundeskreises und des Elternbeirates natürlich auch die Geehrten selbst, nämlich die Schülerinnen der Schule samt ihrer Lehrkräfte, eingefunden.
„Ihr habt euch einen Platz auf dem Podest redlich verdient“, stellte Ramsteiner gleich zu Beginn seiner Ansprache heraus. Die ausgezeichneten Projekte der Schülerinnen würden mehr als deutlich machen, dass an der Maria-Ward-Schule „mit Händen und Herzen gearbeitet“ würde. So sei etwa das Projekt „Herzwerker“, bei dem die Schülerinnen soziale Berufe in Theaterszenen umgesetzt haben, ein Beleg für eine „lebendige, kreative und ausdrucksstarke Berufsorientierung“, wie es der Ministerialbeauftragte ausdrückte.
Ausgezeichnet wurden zudem das Projekt „Hoffnungen und Wünsche“, in dem alle Schülerinnen den Raum bekamen, ihre Hoffnungen, Wünsche, aber auch Ängste und Kritik zu äußern., der Nachhaltigkeitstag der SMV und das Engagement dreier Schülerinnen im Jugendkreistag. Angetan hatte es Ramsteiner ein Tanzprojekt, das einige Zehntklässlerinnen für eine Woche in das ehemalige Konzentrationslager Flossenbürg führte, wo sie unter professioneller Anleitung das unbeschreibliche Leid des Lagers und den Umgang damit in tänzerischer Form verarbeiteten. „Ihr seid eine Schule, die Brücken baut“, sagte der Ministerialbeauftragte.
Gerade diese außerunterrichtlichen Aktivitäten seien doch „die Dinge, die wirklich aus der Schulzeit in Erinnerung bleiben“, betonte Ramsteiner, ehe er Schulleiterin Birgit-Thum Feige und Schülersprecherin Melina Roscher die Urkunde des Staatsministeriums als Anerkennung für die Leistungen überreichte. Umrahmt wurde die Feierstunde musikalisch von der Bläserklasse der Schule und von einem Gitarrenduett.
Folgende Projekte wurden vorgestellt:
„Hoffnungen und Wünsche“, stellvertretend Schülersprecherin Melina Roscher (9c), Projektleitung: Frau Gehr
„Herzwerker – eine szenische Berufsberatung zu sozialen Berufen“, eine Live-Talkshow mit Schülerinnen der achten Klassen
Nachhaltigkeits- und MINT-Tag, stellvertretend Maresa Ganz (10a), Projektleitung: Herr Kytlic
Tanzprojekt im ehemaligen Konzentrationslager Flossenbürg – ein Projekt des Katholischen Schulwerks Bayern, Zoe Radmacher (10a), Marie Schädel (10c) und Greta Schlicker (10c), Projektleitung: Frau Foldenauer
Schülerinnen im Jugendkreistag, Anis Alassani (10a), Zoe Radmacher (10a) und Ida Heinzelmann (10a), Projektleitung: Frau Spindler
Text & Fotos: Andreas Lösche





Die „Philipp-Lahm-Schultour“ an der MWS
In diesem Jahr gehört die MWS zu einer der ausgewählten Schulen, die an der „Philipp-Lahm-Schultour“, die von der Philipp-Lahm-Stiftung und der AOK Bayern auf die Beine gestellt wird, teilnehmen dürfen.
Der erste Teil der Schultour fand bereits statt: Die Aktionswoche. Die Mädchen der 5. und 6. Klassen erfuhren, was eine gesunde und ausgewogene Ernährung ausmacht, weshalb man sich regelmäßig bewegen und auch den Geist fithalten sollte und welche persönlichen Stärken jedes von ihnen besitzt. In Selbstversuchen und Gruppenaufgaben arbeiteten die Schülerinnen an verschiedenen Stationen und hatte viel Spaß dabei. Ein herzlicher Dank ergeht hier auch an die Coaches der Schultour, die die Mädchen begleiteten.
Der Aktionswoche folgen nun weitere Schritte in einer Ideenwerkstatt hin zu einem Schulprojekt, um oben genannte Aspekte nachhaltig im Schulalltag einzubauen.
Wir sind schon gespannt, welche Ideen die einzelnen Klassen sammeln und in der Projektversammlung vorstellen werden. Vielleicht kann das gewählte und durchgeführte Projekt sogar am Ende Philipp Lahm selbst und eine Jury überzeugen und die MWS gewinnt einen Besuch des ehemaligen Nationalspielers an der Schule.
Fortsetzung folgt…
L Rüttger




MINT-Aktion der neunten Klassen an der Maria-Ward-Schule Würzburg
Würzburg, 3. Oktober 2024 – Am 17. September und am 2. Oktober 2024 nahmen die Schülerinnen der neunten Klassen der Maria-Ward-Schule an einem spannenden Projekt der Initiative Junge Forscherinnen und Forscher (IJF) teil. Ziel der Veranstaltung war es, das Bewusstsein der Jugendlichen für die Herausforderungen zu schärfen, die der steigende Energiebedarf und der Klimawandel an unsere Gesellschaft stellen.
Der erste Projekttag war geprägt von interaktiven Elementen wie Virtual Reality, ansprechenden Vorträgen und lehrreichen Experimenten. Die Schülerinnen konnten sich intensiv mit verschiedenen MINT-Themen auseinandersetzen, darunter Photovoltaik, Windenergie, Mechanik und Elektrotechnik. Diese Themen sind nicht nur essenziell für die Umwelt, sondern auch für die Gestaltung einer nachhaltigen Zukunft.
Ein besonderes Highlight war die Team-Werkstatt, in der die Schülerinnen in Gruppen arbeiteten, um ihr Wissen praktisch anzuwenden. Hier wurden nicht nur technische Fähigkeiten geschult, sondern auch Teamgeist und Problemlösungsfähigkeiten gefördert.
Am zweiten Projekttag durften die Schülerinnen dann kreativ werden: Sie entwarfen und bauten ihre eigenen „Zukunftsdörfer“, die effizient mit erneuerbarem Strom versorgt werden sollten. Dabei hatten sie die Möglichkeit, innovative Lösungen zu entwickeln und ihre Visionen für eine nachhaltige Zukunft zu präsentieren.
Die Veranstaltung wäre ohne die hervorragende Organisation der Fachschaft Physik nicht möglich gewesen. Ein besonderer Dank gilt auch den engagierten Wissenschaftlerinnen und Wissenschaftlern der IJF, die mit ihrem Wissen und ihrer Begeisterung die Schülerinnen inspirierten.
Die MINT-Aktion an der Maria-Ward-Schule hat nicht nur das Interesse der Schülerinnen für naturwissenschaftliche und technische Fächer geweckt, sondern auch einen wertvollen Beitrag zur Sensibilisierung für Umwelt- und Klimafragen geleistet. Die Schülerinnen sind nun besser gerüstet, um die Herausforderungen der Zukunft aktiv anzugehen. M. Kytlic



Gesund und Lecker- Montagsfreude

Physik im Advent: Schülerinnen der Maria-Ward-Schule sind wieder dabei!
Auch in dieser Adventszeit nehmen die Schülerinnen der Maria-Ward-Schule zahlreich an "Physik im Advent" (PiA) teil. Dieser besondere Adventskalender bietet jeden Tag eine neue physikalische Herausforderung. Die Veranstalter beschreiben PiA als einen Adventskalender der besonderen Art, bei dem Jungforscherinnen, Jungforscher und alle Interessierten 24 spannende Experimente und physikalische Rätsel entdecken können.
Die Experimente sollen die Freude am Selber-Experimentieren wecken oder beim Zuschauen für Spannung sorgen. Die Schülerinnen sind mit viel Neugier und Begeisterung dabei und freuen sich darauf, jeden Tag ein neues physikalisches Rätsel zu lösen.
Wir wünschen allen Teilnehmerinnen eine spannende Adventszeit voller physikalischer Entdeckungen!
S. Gaubitz (für die Fachschaft Physik)

Herbstfest am Freitag, 20.09.2024
Auch in diesem Schuljahr war uns der liebe Gott wieder wohlgesonnen und hat uns das beste Wetter geschickt, das man sich für ein Schulfest nur wünschen kann. Bei herrlichem Spätsommerwetter feierten wir unser alljährliches Herbstfest. Die vielen Schülerinnen, Eltern, Gäste und Ehemalige konnten sich bei Dosenwerfen, Torwandschießen, Bobbycar-Rallye und vielem mehr die Zeit vertreiben. Am Stand des Freundeskreises informierten die Ehrenamtlichen über den Förderverein unserer Schule und warben um neue Mitglieder. Ein herzliches Dankeschön geht, wie immer, an unsere Schülerinnen und Lehrkräfte, die sich um die einzelnen Stationen kümmerten, sowie an den Elternbeirat mit seinen zahlreichen HelferInnen für die Bewirtung mit Getränken und köstlichen Leckereien, wie Bratwürsten, Currywurst, Wraps oder leckeren Kuchen und Torten. Auch Frau Acosta und Herr Hess sei hiermit herzlich gedankt. Es war wieder einmal ein wunderschönes Schulfest!
S. Kreußer










